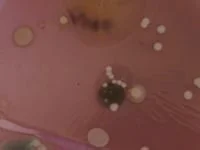

Waking From Time

Haroon Mirza presents an immersive sound installation with the Birmingham Contemporary Music Group, created in collaboration with composer Lucy Armstrong, singer Juliet and videos by Helga Dorothea Fannon.
Re-Creation is a sound installation and performance in which the audience moves through the space, experiencing light, smells, fog and live music.
As an attempt to untether K. F. E. Trahndorff’s concept of the Gesamtkunstwerk from the tropes and conventions of opera, this “adisciplinary” project aims to dilute the distinctions between a myriad of artistic forms. Sculpture becomes set, instrument, and lighting design. Dancer merges with instrumentalist and so on. The work is developed collectively by artists following their own path, working rhizomatically without a director or Conductor.
Evolving from a narrative based on the reincarnation of a murdered healer, this psychedelic piece delves into shamanic death and rebirth from a neurochemical and theological perspective.
Woman as moss

small fires

i plunge

Her